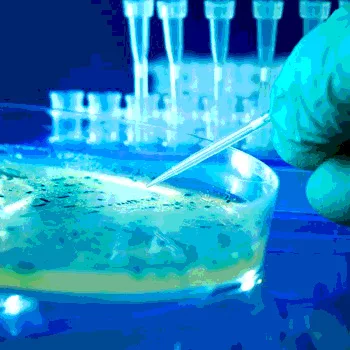

Your Food Contamination Crisis Plan: Four Steps to (Relative) Peace of Mind
Food contamination claims are not only expensive but also potentially devastating to a food provider’s reputation and brand. And while no one expects to be subject to a contamination claim, everyone in the business must be prepared with an appropriate food contamination crisis plan. The cost of not doing so could be the very existence of the company you’ve worked so hard to build.
In addition, such plans are now required under recent amendments to the Food Safety Modernization Act (FSMA). Do you have a plan? And, if so, will it survive scrutiny if the U.S. Food and Drug Administration (FDA) comes knocking? Consider these four steps to assuring that you are protected:
1. Acknowledge the Risk to Your Business
Many food providers operate under the hope that a food safety crisis simply cannot happen to them. However, there is little question that the U.S. government is focusing heavily on food contamination issues. This is motivated in part by a tremendous increase in the number of food contamination and adulteration claims—generally, one such claim is reported to FDA every day. Added to this is a new “culture” within FDA and Department of Justice: one of aggressive enforcement of the Federal Food, Drug and Cosmetics Act and, along with it, the new requirements of FSMA.
2. Establish a Team
If your company doesn’t currently have a food contamination crisis team, you need to establish one. With a team in place, the company can respond not only with the speed necessitated by a food contamination crisis, but also in a thoughtful manner. Little is worse than scrambling upon realizing the need to institute a recall or a market withdrawal.
Your food contamination crisis team will need to include 1) top company officials with authority to make immediate decisions, 2) legal counsel familiar with food production, recalls and market withdrawals, 3) food experts familiar with your production process, 4) regulatory expert and 5) a crisis-management PR provider.
3. Create a Written Plan
The crisis management team needs to create a written plan, ahead of any actual crisis, outlining the process for handling various contamination or adulteration scenarios. The plan should also clearly reflect the current composition of the team and the contact information for each member.
In order to create a comprehensive and aggressive plan, the team should spend some time considering the following:
• The possible risk of food contamination/adulteration at different junctures of its process for growing, processing, packaging and/or transportation of its food products
• The way the company should respond when involved in a worst case scenario
• The manner in which the company officials will communicate with its employees and other outside third parties
• The procedures, if any, that can be put in place now before being faced with a contamination/adulteration issue in order to be prepared for that possibility
4. Put your Plan to the Test
Test what you’ve written. Engage in dry runs. Create hypotheticals and brainstorm potential responses. Review the plan, ideally each quarter, but at a minimum each year. The value of a current and well-thought-out plan simply cannot be understated.
In conclusion, despite the challenges it presents for food providers, a certain level of governmental oversight of food production is both necessary and potentially helpful to the industry. Our government is charged with protecting the integrity of our food supply in an effort to limit the incidence of consumer illness and death from contaminated or adulterated foods. And at the same time, by providing clear guidelines for food safety, the government can protect food providers from unreasonable liability claims.
Government oversight is not going away. So the best that food providers can do is to be beyond reproach in preparing for potential contamination or adulteration scenarios. Yes, this takes an investment of time preparing for something that we hope will never happen. But consider this. Most of us don’t expect our homes to burn down. But we nonetheless invest in insurance policies to protect against such a potentially catastrophic event, despite how incredibly unlikely it is.
Simply put, your food business deserves the investment of time that this simple four-step plan requires. And perhaps you’ll reap the additional reward of a better night’s sleep.
James E. Lozier, Esq., is a member in Dickinson Wright’s Lansing, MI office and is leader of the firm’s Food and Agribusiness Practice Group. He can be reached at 517.487.4775 or jlozier@dickinsonwright.com.
>
Looking for quick answers on food safety topics?
Try Ask FSM, our new smart AI search tool.
Ask FSM →






